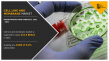

Cell Line and Membrane Market Size Poised to Reach USD 4.5 billion by 2031, Driven by Impressive 8.8% CAGR

PORTLAND, OREGON, UNITED STATES, May 29, 2023 /EINPresswire.com/ -- According to the report, the global cell line and membrane industry is estimated to generate $4.5 billion in 2021 and $10.6 billion by 2031, witnessing a CAGR of 8.8% from 2021 to 2031 …





























